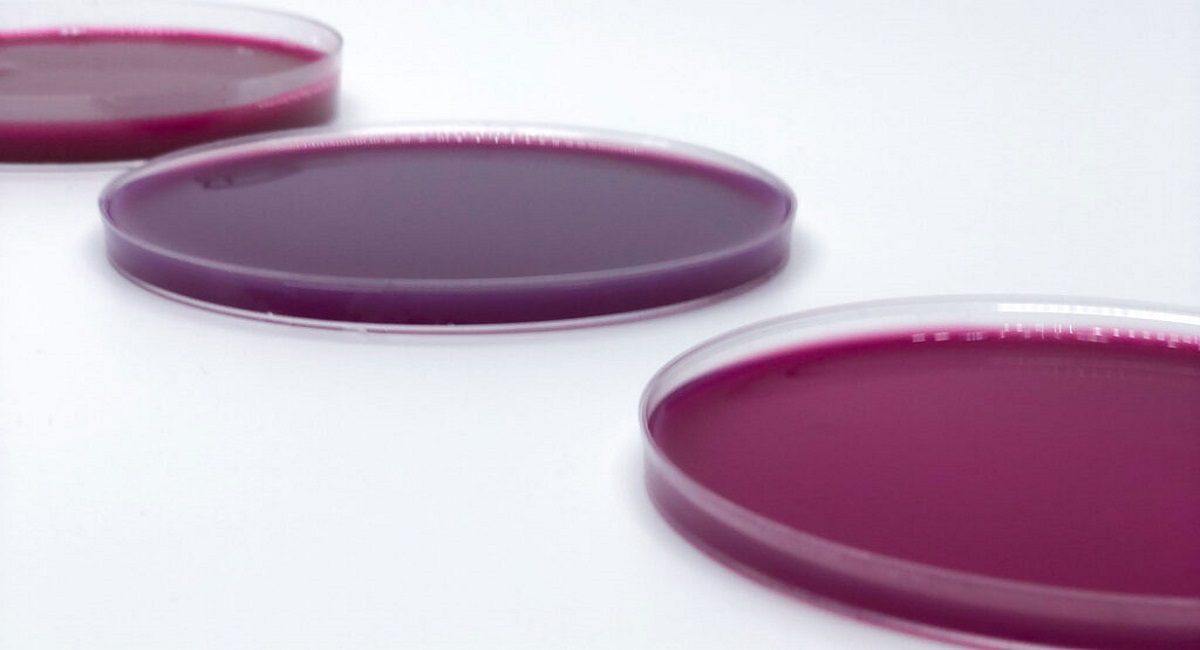

Tiêu đề
Những tin tức nổi bật trong tuần
Xăng E10: Truyền thông quyết định thành công
01/05/2026
Con người lùi bước, thiên nhiên trở lại
28/04/2026
Giỏi nghề chưa chắc giỏi truyền thông (kỳ 6)
24/04/2026
Rừng ngập mặn mở lối cho kinh tế carbon
20/04/2026
Từ Cù Lao Chàm, nhìn lại giá trị của cỏ biển
17/04/2026
Carbon xanh có ý nghĩa gì với bạn?
16/04/2026
Thử nghiệm nhỏ và lời mời đồng hành
14/04/2026
Không phải quán ăn
13/04/2026
Xóm Bướm là gì
11/04/2026
Bản đồ môi trường: vì sao bạn nên quan tâm
11/04/2026
Một khởi đầu nhỏ ở Xóm Bướm
10/04/2026
Kỳ 3: Ở Lào, trồng cây không cần phát động
08/04/2026
Dự báo sai và câu hỏi truyền thông
07/04/2026
VFEJ phác thảo số báo đầu tiên
07/04/2026
Lồng lộng tình người
06/04/2026
Viết thông báo sự kiện: Đừng chỉ “báo tin”
06/04/2026
Bản đồ hóa hành động môi trường toàn cầu
05/04/2026
Viết gì ở dòng đầu để bạn đọc không rời đi
02/04/2026
Muốn tin được đọc, hãy viết theo cách này
02/04/2026
Viết tin khoa học để bạn đọc thực sự đọc
02/04/2026
phát biểu
29/03/2026
Bổ nhiệm thành viên Ban điều hành VFEJ
09/02/2026
Rong biển nâu trong cuộc chiến chống béo phì
03/02/2026
Cộng tác viên – Nguồn tài nguyên vô giá
31/12/2025
Làm tin từ thông cáo báo chí
10/12/2025
Trường hợp Lâm Thao – Kỳ 3
06/12/2025
Trường hợp Lâm Thao – Kỳ 2
06/12/2025
Lịch sử VFEJ
02/12/2025
Vài nét về VFEJ
02/12/2025
Ban Điều hành VFEJ
02/12/2025
Kỳ cuối: Học viện Quân y – Vì sao
25/09/2025
Thời điểm vàng để ăn uống lành mạnh
22/09/2025
Tìm vi khuẩn quý trong rong biển Nha Trang
14/08/2025
Xác định mục tiêu mới cho cơn đau mãn tính
12/08/2025
Gặp gỡ “những sợi mì” của biển Việt Nam
12/08/2025
Trứng giúp giảm nguy cơ mắc Alzheimer
30/07/2025
Rong biển bước ra chính trường toàn cầu
29/07/2025
Giông bão đến – biển dạy ta đứng vững
21/07/2025
Đại dương- “trường học” của sự bền vững
21/07/2025
Hói đầu có thể chữa khỏi không?
14/07/2025
Phụ nữ cứng rắn hơn đàn ông
11/07/2025
Khánh Hòa ‘dẫn đầu’ về chiều dài bờ biển
09/07/2025
Sản xuất xi măng từ nước biển
09/07/2025
Việt Nam phê duyệt Hiệp định về biển cả
12/06/2025
Bảo vệ đại dương: Cần hành động
10/06/2025
Nuôi tôm theo con nước rừng ngập
05/06/2025
Tảo biển – Siêu thực phẩm cho não bộ
05/06/2025
Thua lỗ và thiếu lao động, tàu cá nằm bờ
04/06/2025
Năm lý do vì sao giáo dục biển quan trọng
21/05/2025
Ngăn chặn tôm hùm giống nhập lậu
21/05/2025
“Sức khỏe con người bắt đầu từ đại dương”
12/05/2025
Khi cá voi đi tiểu, đại dương được hồi sinh
09/05/2025
Bạn có thể ăn gân tôm không
08/05/2025
Vịnh di sản hút du khách quốc tế
29/04/2025
Mảng xanh giữa trùng khơi
28/04/2025
Đại dương gọi tên tuổi trẻ
15/04/2025
Dai dẳng sạt lở bờ biển Hội An
20/03/2025
Rong biển có phải là rau không?
13/03/2025
Phát triển thuốc nhuộm từ rong biển
10/03/2025
Cảng cá hơn trăm tỉ chỉ 1 tàu neo đậu
10/03/2025
Vịnh Lăng Cô bị rác bủa vây
05/03/2025
Cá nóc: Một quả bóng bay tử thần dưới nước?
04/03/2025
Sự thật thú vị về Omega-3 từ tảo biển
03/03/2025
Bọt biển có thể chữa được ung thư không?
02/03/2025
Nên bổ sung bao nhiêu omega-3 mỗi ngày
02/03/2025
Ngày cho Omega – 3 EPA và DHA
02/03/2025
Bệnh bí ẩn ở Congo liên quan tới môi trường
28/02/2025
Axit hóa đại dương là gì?
27/02/2025
Vinh danh du thuyền trên Vịnh Hạ Long
27/02/2025
Ngư dân đi…. học tiếng Anh để làm du lịch
27/02/2025
Doanh nghiệp Việt Nam và hành trình Net Zero
24/02/2025
Rong biển hỗ trợ sức khỏe tuyến giáp
21/02/2025
Bò biển dugong bơi sát bờ biển ở Côn Đảo
19/02/2025
Sự thật về cua biển khiến bạn phải suy nghĩ
19/02/2025
Phú Hải ra quân đánh bắt thủy sản đầu năm
17/02/2025
Thiêng liêng cờ Tổ quốc trên biển
13/02/2025
AL phân tích dữ liệu để đánh bắt cá tối ưu
10/02/2025
Xây dựng thương hiệu du lịch Ninh Thuận
10/02/2025
Lễ xuất quân đánh cá vụ Nam năm 2025
10/02/2025
Ra khơi đón lộc biển đầu xuân
10/02/2025
Vươn khơi đầu năm lấy ‘lộc biển’
06/02/2025
Ghe tàu rộn ràng xuất hành đầu năm
04/02/2025
Đẩy mạnh thu hút đầu tư vào Vân Phong
04/02/2025
“Mở biển” đầu năm
04/02/2025
Ngành đóng tàu khởi sắc mạnh mẽ
04/02/2025
Tín chỉ carbon: Ai bán, ai mua?
02/02/2025
Đầu năm rắn xem bộ sưu tập rắn biển
30/01/2025
Điều gì xảy ra nếu cáp quang biển bị đứt?
23/01/2025
Xác cá voi 300 kg dạt vào bờ biển Quảng Trị
14/01/2025
Cấp bách phòng chống sạt lở
13/01/2025
Trồng hàng nghìn tấn rong sụn, rong nho
07/01/2025
Sinh kế bền vững cho cộng đồng ven biển
31/12/2024
Gỡ vướng để đón tàu lớn vào cảng
31/12/2024
Áp lực đa dạng sinh học biển Cù Lao Chàm
13/12/2024
Tại sao bạn nên làm xét nghiệm omega-3?
11/12/2024
Lý do sản lượng bột cá toàn cầu tăng vọt
03/12/2024
Từng bước chinh phục biển sâu
29/11/2024
Thị trường Omega 3 sẽ tăng trưởng kép
25/11/2024
Những huyền thoại về Omega-3
25/11/2024
Sự khác nhau giữa đại dương và biển
25/11/2024
Phát triển kinh tế biển bền vững
21/11/2024
Rong biển như thức ăn cho não
20/11/2024
Sáu lợi ích của hải sản với trẻ em
05/11/2024
Bao giờ dân ta được ăn rong biển của ta
30/10/2024
Dự đoán bùng nổ bán lẻ rong biển năm 2025
29/10/2024
Bãi tắm Phú Thuận tan hoang sau bão Trà Mi
28/10/2024
Nơi sống có ảnh hưởng đến thói quen ăn uống?
24/10/2024
Giảm rác thải nhựa, phủ xanh Côn Đảo
22/10/2024
Cua ẩn sĩ dần coi rác thải nhựa là nhà
22/10/2024
Phát hiện vi nhựa trong hơi thở của cá heo
21/10/2024
Cách trồng vàng xanh
21/10/2024
Chúng ta có đang ăn đúng loại hải sản không?
16/10/2024
Lặn sâu về rong biển
16/10/2024
Công nghệ hữu ích cho ngành thủy sản
15/10/2024
Độc đáo- kết hợp tảo vào bữa trưa ở trường
14/10/2024
Tảo bẹ vào thực đơn của các trường học
08/10/2024
Omega-3 có trong hải sản giúp giảm sinh non
07/10/2024
Đại dương: Một xa lộ đầy lông vũ
02/10/2024
Ra mắt sáng kiến carbon xanh độc đáo
30/09/2024
Lấn biển tạo đà phát triển
30/09/2024
Hàm lượng Omega-3 trong các sản phẩm hải sản
26/09/2024
Biến cá xâm lấn thành cơ hội vàng
26/09/2024
Cá vây tay, một di tích sống từ thời tiền sử
17/09/2024
Loại rong biển nào có hương vị ngon nhất
16/09/2024
Vì sao trẻ kém và sợ toán
09/09/2024
Trẻ nên biết tác hại của rượu
09/09/2024
Hỏi con sau giờ tan trường
09/09/2024
Đối xử với trẻ như người lớn (Kỳ cuối)
07/09/2024
Đối xử với trẻ như người lớn
07/09/2024
Thiên tài nhí vào đời bất hạnh
06/09/2024
Lắng nghe nhu cầu của trẻ
05/09/2024
Tảo bẹ là gì và tại sao chúng ta nên ăn nó?
04/09/2024
Thiếu ôm ấp, trẻ què quặt tâm lý
02/09/2024
Nấm biển có khả năng phân hủy rác thải nhựa
28/08/2024
Nên để trẻ nhàm chán cao độ
28/08/2024
Omega-3 có thể làm giảm sự hung hăng tới 30%
28/08/2024
Người trẻ lặn biển cứu san hô
28/08/2024
Ra mắt công ty khởi nghiệp tôm từ thực vật
26/08/2024
Truy tìm nguồn gây ô nhiễm biển từ cảng biển
26/08/2024
Nở rộ giáo dục sớm ở Mỹ
26/08/2024
Cảng xanh là gì?
26/08/2024
Trang trại nuôi tôm và carbon xanh
21/08/2024
Phố và quê
19/08/2024
Thúc đẩy văn hóa xanh
15/08/2024
Phát triển hạ tầng bền vững
15/08/2024
Chiến lược cảng xanh
15/08/2024
Công nghệ xanh và đổi mới sáng tạo
15/08/2024
Trồng rừng ngập mặn ứng phó thiên tai
06/08/2024
12 lợi ích cốt lõi
03/08/2024
Kỳ 3 – Gáy như gà sủa như chó
03/08/2024
5 cách dạy trẻ em bảo tồn đại dương
01/08/2024
Đại dương đang nghẹt thở vì nhựa
23/07/2024
Kỳ 2- Khả năng học trong vô thức
22/07/2024
Giáo dục sớm có quá sớm
22/07/2024
Cùng độc giả
22/07/2024
Kiểm tra dự án 22 ha rừng ngập mặn
11/07/2024
Các khoản tài trợ nhỏ
11/07/2024
Tuổi trẻ thông thái về đại dương
08/07/2024
Bộ giáo dục đại dương
08/07/2024
Ứng xử với rác thải trên biển
08/07/2024
Ngành dệt may Việt Nam xanh hóa đến đâu?
04/07/2024
Quần áo làm từ lá dứa
03/07/2024
Đặc tính dinh dưỡng của rong biển
19/06/2024
Trải nghiệm làm “nàng tiên cá” dưới biển
19/06/2024
Rong biển có siêu năng lực
19/06/2024
Rong biển tốt cho sức khỏe não bộ
03/06/2024
Giữ rừng san hô Côn Đảo
29/05/2024
Tảo bẹ là một siêu thực phẩm tuyệt vời
14/05/2024
Bộ công cụ khám phá
13/05/2024
Kiến thức đại dương
13/05/2024
Đặt một hội thảo phát triển chuyên môn
13/05/2024
Đặt một chương trình ảo
13/05/2024
Trải nghiệm đại dương ảo
13/05/2024
Năm 2024 có thể là năm nóng nhất
08/05/2024
Bảo vệ đại dương từ đất liền
02/05/2024
Chủ bè tôm thu gom rác bảo vệ môi trường
23/04/2024
Tiền bán tín chỉ carbon đã về
12/04/2024
“Lá phổi của biển” đang ốm
09/04/2024
Động vật cũng nằm mơ khi ngủ
03/04/2024
Hải sản bền vững
03/04/2024
Biển Đông: Siêu Xa Lộ Thương Mại
03/04/2024
Làng chài cuối cùng trên phá Tam Giang
20/03/2024
Tính năng live trực tiếp
16/03/2024